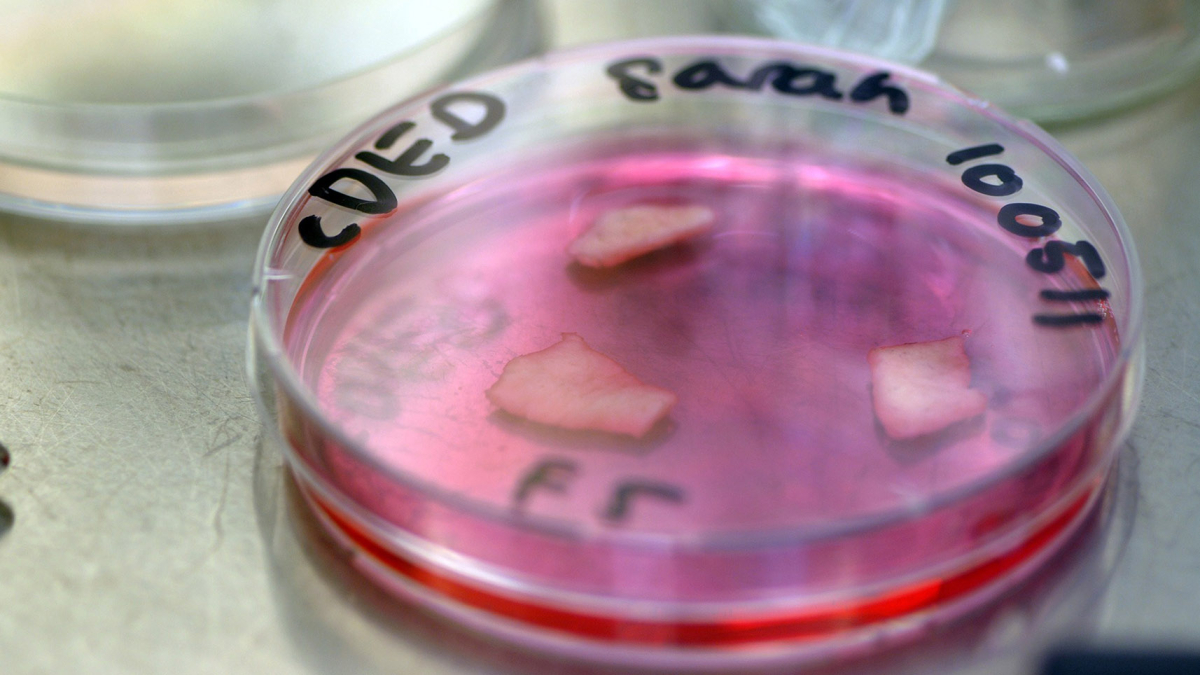
Inzet Jalila

When spider silk meets human skin
A pioneer of Dutch bio-design, where art, science, and biotechnology meet.
From bulletproof skin to clothing made from manure, Jalila Essaïdi transforms scientific breakthroughs into poetic statements about the future of humanity and nature. Her work is visionary, experimental, circular, and collaborative.
Essaïdi first gained worldwide attention with her project 2.6g 329m/s, also known as ‘Bulletproof skin’. Working with scientists at her own BioArt Laboratory in Eindhoven, she integrated spider silk, one of the strongest natural fibres on Earth, into human skin cells. The result: a hybrid material strong enough to stop a bullet fired at reduced speed. What began as an art experiment soon became a catalyst for global conversation about how which forms of safety would benefit society.

Essaïdi explores the social, political, ethical, and cultural questions that arise in a world shaped by new biotechnologies. Project 2.6g 329m/s received international attention and even drew interest from the U.S. military. Rather than selling her patent to the highest bidder, Essaïdi turned her invention toward healing. The same silk-based material is now being developed as a regenerative dressing for burn victims and chronic wounds, turning protection into restoration - a natural, biodegradable skin that helps the body heal itself.
Isolated dermis, used to extract fibroblasts from.

A bullet wrapped in a piece of in vitro skin attached to a block ballistic gell.
Her curiosity didn’t stop there. Through her biotech company Inspidere, Essaïdi created Mestic®, an innovation that transforms cow manure into textiles, paper, and bioplastics. The project challenges our instinctive aversion to waste. Because in nature, nothing is truly waste. By revealing the hidden value of what we discard, Mestic® shows that even the most unpleasant materials can hold beauty and potential. By turning waste into value, she redefines what circular design can look like.

Essaïdi is the CEO of Inspidere B.V., a biotech company based in the Brainport region of Eindhoven. She continues to mentor the next generation of bio-designers at her BioArt Laboratories, developing nature-based solutions for global challenges such as CO₂ capture and sustainable materials. It fosters collaboration between life sciences and the creative industries. Jalila Essaïdi embodies New Dutch, where innovation grows from curiosity, collaboration, and the belief that nature and technology belong on the same team.
Learn more about Jalila Essaïdi


#newdutch is a mentality, a movement, and an international platform for Dutch innovation.
Check out these other New Dutch cases
Get in touch
Does #newdutch spark an interest or a golden idea with you? We love hearing from you! You can email us at newdutch@nlbranding.nl

